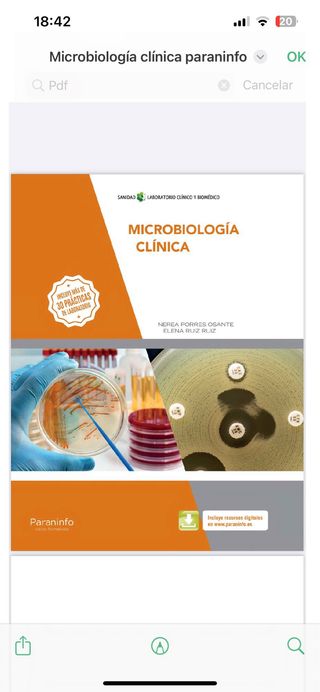

Libros de física de segunda mano Algeciras
Novedades

Física 2º Bachillerato
Libro de física para segundo de bachillerato.
Física y química. 3 ESO. Savia. Andalucía
Libro en muy buen estado y bastante cuidado.
Curso de Química Física. En dos tomos.
Curso de Química Física. En dos volúmenes. Segunda Edición. Varios autorrs: Guerasimov, Dreving,Eriomin, Kiseliov... Las sobrecubiertas estan rotas pero l8s libris están bien
N6eva Guía de las Ciencias Físicas
Libro divulgacion científica
Fisica y Química
Libro de 1° bachillerato junto con libro de formulación y nomenclatura químicas. Como nuevo
Libro física 2 Bachillerato
Vendo libro de física de la editorial Ofxord nuevo. Está forrado y conserva todas sus páginas en perfecto estado. Cualquier duda hágamela saber.
Libro de Física 2.º Bachillerato. Oxford
Libro de Física nuevo
Libro Física y Química 1º Bachillerato
En buen estado
Libro de Física y Química de Bachillerato
Libro algo desgastado pero perfectamente utilizable. El libro está plastificado.
Libro de texto física y química 3° eso santillana
Está en buen estado

Educación Física 1
Como nuevo

Maldita física
Esta nuevo sin uso

Física 2.º Bachillerato.
Libro texto

Física y Química 1o Bachillerato.
Tiene algunos desperfectos en el exterior, pero el interior está en perfectas condiciones. Precio negociable.
Educación Física 6
Usado solo un curso escalera, sin Subrayar ni hacer anotaciones.
Física y Química 1.º Bachillerato. NOVA
Tapa deteriorada, el resto en buenas condiciones
Física y química. 4 ESO. Savia Nueva Generación...
Sin anotaciones ni tachaduras
Educación Física 1. (Spanish Edition)
Libro de EF de 1° de ESO de la editorial ANAYA, el libro cuenta con alguna página subrayada pero nada desgastado.
Física y Química 1.º Bachillerato. Mc Graw Hill
Libro Física y Química
Fisica y Química 1ºBachillerato
El libro está en buen estado y forrado.
Módulos Transversales - Libro de texto en forma...
Libro de texto en formato físico de Formación y Orientación Laboral Clave actualizado con las últimas modificaciones legislativas de la reforma laboral.
Física y química. 1 Bachillerato. Savia
precio negociable
Física y Química 3ero de la ESO ANDALUCÍA
Libro en perfectas condiciones, sin forrar, nuevo y sin pintadas en las páginas .
La fisica del alma
Doctor amit goswami. Ediciones obelisco. Tapa blanda. Nota tiene subrayado algunas páginas a lápiz. Más artículos escribiendo algeral en búsqueda general. Se hacen lotes en conjunto con los otros perfiles. Tengo más libros en otro perfil.
Colección Cursos de Física COU
Colección de 3 tomos de Física para COU emitido por el Instituto Nacional de Bachillerato a distancia.
Libro Fisica y Quimica Bruño 1° Bach
lo compre por la web de plataformadelestudiante y esta super bien cuidado practicamente nuevo
libro fisica y quimica anaya 1 bachillerato
el libro esta perfecto con algunas marcas en lapiz que se pueden borrar facilmente
Libro Física y Química 1° Bachiller
Editorial Bruño
Fisica y química 1 bachillerato
Libro de física y química de 1 bachillerato MC GRAWHILL

Libro de física y química
libro física y química 1 de bachillerato
Libro 2° bachillerato física.
libro 2° bachillerato física. Oxford Educa. entrega en mano. no hago envíos.
Libro de física química 1° bachillerato
libro de Física y Química de 1° de bachillerato en perfecto estado
PACK LIBROS LABORATORIO CLINICO Y BIOMEDICO
Libros en pedeefe, no fisicos. Son del grado superior de laboratorio clinico y biomedico El precio es por el pack.
Libro de fol
libro nuevo libro fisico

Libro de frances
Nada de uso Libro fisico
Libro de Física y Química 1º bachiller Anaya
Está en perfectísimas condiciones. Para más información no dudes en escribirme.

Física y química 1 bachillerato
ISBN 978-84-675-7651-1
Fisica y Quimica 1 bachillerato SM
ISBN 978-84-675-7651
Libro
vendo libro de educación física 4 ESO Bruño

Libro preparación acceso universidad
2 ESO física y química Bruño
PACK LIBROS AUXILIAR DE ENFERMERIA
Estos libros yo los use el año pasado, no son en físico. PRECIO PACK 6€
Primeros auxilios (2.ª edición revisada y actua...
Primeros Auxilios es un módulo profesional, transversal, que se estudia en cuatro familias profesionales como son: la familia de Sanidad, la de Servicios Socioculturales y a la Comunidad, la de Transporte y Mantenimiento de Vehículos y la de Actividades Físicas y Deportivas. Este libro tiene como objetivo capacitar a los alumnos que cursan alguno de estos ciclos formativos, y a la población en general, en la realización de las técnicas y procedimientos necesarios para efectuar una actuación básica responsable, de calidad y eficiente hasta la llegada de los servicios de emergencias. Cuando se habla de Primeros Auxilios siempre se pie
Futbol / Soccer: Preparacion Fisica Moderna/ Mo...
Futbol / Soccer: Preparacion Fisica Moderna Jef Sneyers. Tapa blanda. Preparacion Fisica Moderna. Hispano Europea. Esquemas prácticos y ejercicios. 1989. Otro libro de preparación física futbol en mi perfil ( guía del entrenador de fútbol ). Ambos x 8€. Colección coleccionista coleccionismo Más artículos escribiendo algeral en búsqueda general. Se hacen lotes en conjunto con los otros perfiles.
Educación Física 1.
Libro educación física

FÍSICA Y QUÍMICA
Fisica y quimica
Educación Física 1
Libro nuevo, sin usar. Comprado por error.
Física y Química 1.
Libro de física y química ANAYA 1 bachillerato
Generación B Educación Física 4 ESO
libro educación física ISBN 9788469631867
Educación física.
Libro educación física 2 ESO
Física y Química 1.º Bachillerato
Sin subrayar, está en buen estado. No bajo precio.
Libro 1bachillerat física y química Sava
Libro de física y quimica, esta como nuevo, sin pintar ni nada y ademas forrado.

Física para la ciencia y la tecnología, Vol. 1: Mecánica, oscilaciones y ondas, termodinámica
Libro de universidad de física usado sólo 1 mes
Libros de 2 de ESO
Libros de segundo de la ESO: Geografía e historia Educación plástica visual y audiovisual Tecnología Lengua Castellana y Literatura Fisica y química Inglés 12 EUROS CADA UNO
Física y Química 1° Bachillerato
Libro de Física y Química de 1° de bachillerato, con un enfoque metodológico que responde a los criterios PAU. Se centra en plantear numerosos problemas y casos prácticos, así como en mostrar y analizar exhaustivamente los principios y fundamentos teóricos. Datos del Producto: Editorial: Oxford. ISBN: 9788467338812. Encuadernación: Tapa blanda. (plastificado). Exterior de la tapa algo deteriorado. El interior completamente nuevo sin daños.
Libros de 2 de la ESO
Es un pack de libros. Son 5 libros: Matemáticas, Lengua Castellana y Literatura, Inglés, Geografía e Historia y Física y Química. Si queréis podéis forrarlo. No están pintados ni rotos. Está en muy buen estado. Son libros de secundaria.

Libro "La izquierda al poder en Colombia"
Formato Libro físico Autor León Valencia Agudelo Editorial Grupo Planeta Año 2022 Idioma Español N° páginas 208 Encuadernación Tapa blanda Dimensiones 15 x 23 cm NUEVO SIN ABRIR EN SU PLÁSTICO ORIGINAL
Lote 2 guias de fútbol
Lote pack de 2 libros. 1 Guia práctica del entrenador de fútbol Editorial Augusto Pila Teleña. Tapa blanda. 1986. Hugo Tassara Olivares. 2 Futbol / Soccer: Preparacion Fisica Moderna Jef Sneyers. Tapa blanda. Preparacion Fisica Moderna. Hispano Europea. Esquemas prácticos y ejercicios. 1989. Más fotos de cada uno en mi perfil. Coleccionista coleccionismo colección.
Física y Química. 1 Bachillerato. Revuela
Estado totalmente nuevo, sin usar y viene ya forrado.
FISICA Y QUIMICA 1 BTO CONSTRUYENDO MUNDOS
Física y química 1°bachillerato nuevo, sin usar
Física 2.
Libro perfecto para llevar esta asignatura adelante para la Selectividad. Cuenta con claras explicaciones del temario a dar este curso y con muchos ejercicios para practicar y resueltos.
Física y Química 1.
Libro en muy buen estado, ideal para estudiantes que cursan bachillerato. Incluye teoría explicada, ejemplos resueltos, bastantes ejercicios y esquemas para practicar tanto la parte de Física como la de Química. Contenidos actualizados y adaptados todo lo necesario para aprender en estos dos cursos de bachillerato. Muy útil para repaso y estudio autónomo
Geografía general I. Geografía Física
Libro nuevo, sin usar.
Maldita física
Libro de Maldita física en perfecto estado sin uso
Libro Fisica y Quimica
Bachillerato 1. Física y química
Libro 1 bachillerato Física y Química
Libro de 1 de bachillerato Física y química